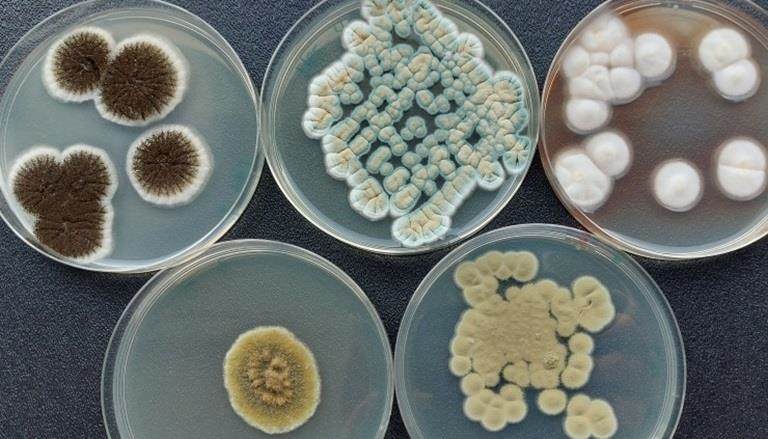

News and Opinion
Keeping you up to date with what's happening at Incotec around the world. Here you can find the latest news about our business, events, new product launches and seed industry insights.

25 years of seed enhancement in South America
22 May 2025: A quarter century of innovation growth and service positions Incotec to meet customer needs and the rising demands of the market in the region.

Incotec sponsors golf prize donation to charity
22 May 2025: Winners of the ISF golf tournament choose the charity to receive a 5000 euro donation from Incotec.

ISF and Incotec renew partnership
20 May 2025: Incotec formally commits to supporting ISF for the coming years by renewing the sponsorship contract for the ISF golf tournament.

Incotec at ISF World Seed Congress 2025
22 May 2025: A global team from Incotec was at the 2025 World Seed Congress. From the many meaningful conversations with industry peers, three prevailing themes stand out.

OPINION: Why priming is needed for X-ray upgrading
7 May 2025: Learn how seed priming supports the X-ray upgrading of seeds to maximize the number of useable transplants in a seed lot.

New production area in Argentina
16 April 2025: The new production facility enables 5 times more seed enhancement production capacity in South America

OPINION: The impact of salt stress on onion root formation
15 April 2025: Barry Hoff, Lead Research Scientists, Abiotic Stress Mitigation, discusses the effects of salt stress on onion growth and development and explores mitigation techniques.

Jonas Altoe Global Head of R&D
24 March 2025: As of March 1, Jonas Altoé is appointed Global Head R&D for Incotec. Jonas will also continue to manage the R&D team at Incotec headquarters in Enkhuizen.

OPINION: Navigating germination challenges in Asia in a changing climate
19 March 2025: The germination challenges tropical crops face due to climate change and how innovative solutions can help farmers succeed.

Huib Koerts new Sales Manager Vegetables in EMEA
18 March 2025: Huib Koerts will start as Sales Manager at Incotec on 1 April. He has 25 years of experience in the agricultural and seed sector. Huib will be responsible for all vegetable sales in the...

ISF golf prize supports good cause
8 January 2025: The winners of the ISF 2024 golf tournament have donated the cash prize provided by Incotec to Seed Programs International

Seed enhancement for field crops at ASTA
9 December 2024: At the North American Field Crops Convention taking place in Florida (10-13 December), Incotec’s William Olson and Jeff Hein are eager to connect with customers and discuss the latest...

Most educational booth at ASC 2024
10 December 2024: Incotec awarded prize for most educational booth at ASC 2024. This year we showcased seed technologies that contribute to sustainabily achieving food security in Asia .

OPINION: How sustainable is seed priming?
5 December 2024: Seed priming is an effective technique, but how sustainable is it? Discover how different pre-germination techniques score on sustainability

Showcasing innovative solutions at ASC 2024
29 November 2024: A team from Incotec will be in Booth SB09 showing seed enhancements for Asia at the Asian Seed Congress 2024. Incotec Asia combines advanced technology with local expertise to...

OPINION: Priming seeds - DIY or outsource to a supplier ?
16 October 2024: What is the advantage of priming seeds in-house? Or is it better to outsource this work to a specialised service provider? Henry Bruggink, Senior Research Scientist, shares some...

Bruno Hoeltgebaum shares views in Seed World
8 October 2024: Bruno Hoeltgebaum, Business Director at Incotec, is one of the experts discussing regenerative agriculture in an article in Seed World Europe.

New film coat for sunflower launched at Euroseeds
03 October 2024: Introducing the newest microplastic-free top performer. Disco Blue L-1523 was developed to meet customer requirements for an intense blue film coat.

OPINION: Does film coating affect seed performance?
01 October 2024: In the first of a series of articles, Carolina Pereira Cardoso discusses the benefits and challenges of seed film coating, and how it contributes to seed vigor and crop yield.

Incotec lecture at Seed meets Technology
10 September 2024: At Seed meets Technology on 24 September, Incotec’s Brechje Veerman and Chloé Martin will deliver a lecture on what regenerative agriculture is, and what it means from a seed...

OPINION: Rhizobia in sustainable ag: specificity is key
12 September 2024: Unlock the potential of rhizobia in sustainable agriculture. Learn how these bacteria aid nitrogen fixation and promote sustainable agriculture for the future.

OPINION: The role of Pseudomonas: friend or foe in agriculture
19 September 2024: Carola Peters explores the significant role of Pseudomonas in plant growth promotion, disease control, and sustainable agriculture practices.

OPINION: The Bacillus family has it all: biostimulant, biofungicide, bioinsecticide
29 August 2024: Due to their many beneficial effects, there are several uses of Bacillus spp. in agriculture. But who does what, and how does it work?

OPINION: The challenges of applying microbes to seed
06 August 2024: The challenges that come with each seed coating method when it comes to direct application of compounds such as microbes, nutrients and plant protection products.

OPINION: Mitigating abiotic stress in crops
19 June 2024: Abiotic stress from factors like drought, salinity and temperature, poses significant challenges. Our paper looks at strategies to enhance crop resilience and mitigate these challenges.

Incotec and Croda release whitepaper on abiotic stress
27 may 2024: The report 'Mitigating abiotic stress to create resilient crops' has been produced with input from the top experts in the field from Incotec and Croda as well as from other sources

Fad or Future?
14 May 2024: In the first of a two-part article in Seed World Europe, industry experts, including Bruno Hoeltgebaum, Business Director at Incotec, share their views and tell us what companies like...

Incotec promotes partnerships for sustainability at ISF’s Holland Pavilion
07 May 2024: Incotec is open for smart partnerships with other companies and institutions, especially if this means accelerating in the fields of sustainability and innovation.

Incotec's Rob Pronk among experts views in Seed World article
08 May 2024: In a recent article in Seed World, Rob Pronk is one of the experts sharing views on the move toward more sustainable agriculture, the importance of seed treatment in achieving that, and...

Highlighting global presence and local solutions at ISF 2024
07 May 2024: This year the World Seed Congress celebrates 100 years of the International Seed Federation (ISF). At this special edition of the annual congress, Incotec shows that it is a truly global...

Han Botterhuis Incotec on Seed Valley Board
09 April 2024: Han Botterhuis, site director Incotec Europe, has joined the Seed Valley Board.

Reducing Effluent Water Disposal
Reducing effluent water disposal at our facility in South Africa is an example of Incotec's commitment to becoming more sustainable

Seed Technology central theme at Thai workshop
5 March 2024: Incotec’s Ernest Fong, Business Development Manager, and Tomoko Sakata, Research and Technology Manager Asia Pacific, will address a number of advanced seed technology topics as key...

UPDATE: Sustainable innovation from seed to harvest
28 February 2024: We have updated our booklet ‘Sustainable innovation from seed to harvest’. Download here and learn how we leverage smart science to maximize land productivity and support the UN's...

Incotec donates to Food Bank West-Friesland
14 February 2024: In an internal competition (the "Purpose In Action Award") Incotec won an award in the Health, Safety and Welfare category for working with ambassadors who are committed to further...

Seed Technology Seminar Thailand
23 January 2024: What can seed technology do for crops in Thailand? In a seminar on Feb 1st Incotec’s Tomoko Sakata and Ernest Fong will update you on the benefits and newest developments

Embracing the spirit of Christmas
19 December 2023: Employees donate their Christmas gift allocation and Incotec donates a further 1000 euros to the same charity.

OPINION: 5 new techniques for priming
28 November 2023: In this article Henry Bruggink dives into some new techniques for priming. The focus will be on techniques for which a patent application was made.

OPINION: 4 key solutions to support sustainable agriculture
14 November 2023: Asia's agricultural industry is under threat. Seed enhancement can play a role in transitioning to more sustainable agriculture

Incotec India celebrates 20 years with dual event
20 October 2023: Anniversary celebrations at Ahmedabad followed by a tree planting event at Mankol School.

Opinion: The 3 standard techniques for seed priming
31 October 2023: This most recent article by Henry Bruggink, specialist in seed priming at Incotec, explains the three standard techniques for seed priming.

OPINION: 7 aspects to consider when priming seeds
03 October 2023: In the second article in this series, Incotec's priming specialist, Henry Bruggink, explains what needs to be considered when improving seed quality through priming.

Plantum Sustainability Award 2023
21 September 2023: The Plantum Sustainability Award was presented to Marion Smorenburg of Incotec by Marien Valstar of the Dutch Ministry of Agriculture, Nature and Food Quality. Incotec wins the...

Aquarela - new film coating facility Brazil
14 September 2023: Incotec has opened a new film coating production facility, named “Aquarela” at the Incotec site in Holambra, Brazil. This expansion is a response to the growing demands of the film...

Nomination Plantum Sustainability Award
12 September 2023: Incotec's efforts in seed enhancement for speeding up reforestation have resulted in a nomination for the Plantum Sustainability Award. The winner will be announced on 21st...

OPINION: 5 questions about the priming of seeds
05 September 2023: The priming of seeds for agriculture is an effective way to improve germination. In the first of a series of articles, Henry Bruggink answers some questions about this powerful seed...

OPINION: Delivering microbial formulations
14 August 2023: How can combining knowledge, expertise and capabilities across different agricultural markets help overcome some of these challenges?

Incotec sponsors golf prize donation to charity
13 June 2023: As sponsor of the ISF golf tournament, Incotec has provided 5000 euros for donation to winners charity

Incotec, world seed congress sponsor, extends invitation for discussion
17 May 2023: At this year's ISF World Seed Congress, Incotec invites attendees to stand SB-503 to discuss the role of seed treatment in the challenges facing the sector.

OPINION: Three ways to get microbes in the right place at the right time
09 May 2023: That microbes can have a positive impact on plant development is no secret, but how can you get the microbes to the right spot at the right time?

Marcia Werner speaks at FAO regional conference
18 April 2023: Marcia Werner, Incotec's R&T Director, speaker in FAO 'No good crops without good seed' event

Whitepaper: Formulating Biologicals for Agriculture
12 April 2023: Incotec and Croda Crop Protection have released a whitepaper on biologicals in the agrochemical sector: the potential and the challenges.

Investing in site Enkhuizen
27 March 2023: Incotec is investing in the future with plans to further develop the site in Enkhuizen, The Netherlands.

Incotec and Land Life join forces to accelerate global reforestation
23 March 2023 : Seed enhancement company Incotec and tech-driven reforestation company Land Life have signed an MoU to collaborate in a pioneering project integrating smart coating technologies on...

Seed pelleting helps combat food insecurity
28 February 2023: Seed pelleting provided by Incotec and financial support from The Croda Foundation enable USA charity 'America's Grow-a-Row to provide more healthy food for the needy.

Indian Seed Congress
28 February 2023: A team from Incotec India will be offering advice and expertise on seed technology for the Indian market from their booth at the Indian Seed Congress.

Sharing seed enhancement expertise at Bangladesh Seed Congress
9 February 2023 : In the Incotec booth, seed technology experts are on hand to discuss the right solution for your crop needs.

OPINION : Microbes eating insects
Microorganisms play an important role in life on earth. Also, in agriculture they can be major contributors to a sustainable world. There is a group of microorganisms that can be classified as bio...

Chapter on priming by Henry Bruggink in new book on sustainable crop production
21 December 2022: Henry Bruggink, senior researcher at Incotec, has contributed to the recently published book Advances in seed science and technology for more sustainable crop production. In the book...

OPINION: The fight against soil borne pathogens
Microorganisms can use different modes of action to protect the plant. In the third blog on the use of microbes in agriculture Carola Peters explains what these are.

New color pigment added to product range
29 November 2021: This valuable addition to the product range is in answer to customers’ requests for a full portfolio of seed enhancement products.

Nathen Deppe appointed general manager of Incotec's North American business
22 November 2022: Incotec announces the appointment of a new general manager in North America. Nathen Deppe has an extensive background in agriculture and a proven track record. His knowledge of the...

New president of APSA
Asian Pacific Seed Association elect Manish Patel, Managing Director of Incotec India, as president.

Incotec and Croda publish recommendations for seed industry on transition to microplastic-free treatments
17 November 2022: We have developed expertise on assessing whether products contain microplastics and on producing new microplastic-free alternatives. The whitepaper provides in-depth information on...

OPINION: Invisible creatures that help the plant thrive
In the second blog of this series on microbes, Carola Peters tells us how microbes can provide the three main nutrients a plant needs.

Opinion: Going microplastic free: lessons from Croda and Incotec’s seed treatment journey
The transition to microplastic-free seed coatings is a challenge for the whole seed industry. Marta Dobrowolska-Haywood talks about the approach taken by Incotec and Croda and what steps they will...

Opinion: The new microplastics legislation - what does it mean for seed treatments and coatings
Marta Dobrowolska-Haywood blogs on the new restrictions of microplastics and the consequences.
OPINION: Superpowers of microbes
In this first blog of a series about microbes and how they can benefit agriculture, Carola Peters describes some of the remarkable qualities of microbes..

Incotec's Marcia Werner speaks at FAO's Global Congress
19 October 2022: With a presentation entitled 'Seed Technology to Upgrade Crop Sustainability', Incotec's Research and Technology Director talks on how applied seed technology contributes to the UN...

ISF golf tournament prizes donated to Red Cross
30 May 2022: The winners of the golf tournament, Mr. Chiaravanond Manas and Ms. Kietisirikajorn Supaporn decided to donate their prizes, provided by Incotec, in the name of the company they both work...

Renewed partnership with ISF
16 May 2022: Incotec will continue to support the International Seed Federation for the coming three years. With the agreement Incotec continues to be one of key partners for the ISF with particular...

Incotec and Solynta announce partnership
16 May 2022: Incotec and true potato seed breeder Solynta announced at the International Seed Federation (ISF) congress today, May 16th, that they have entered in a collaboration agreement to optimize...

ISF World Seed Congress 2022
11 May 2022: More sustainable seed enhancement to come under Mission Zero. Incotec is providing information in booth 35 at the ISF congress in Barcelona on 16-18 May.

Incotec lecture on X-ray at ISTA congress
08 May 2022: Henry Bruggink will explain the use of X-ray in seed analysis and seed selection and talk about the software used for selection and how this relates to the ISTA rules..

Continued support for De Drom in Enkhuizen
02 May 2022 : Incotec will continue to support cultural centre De Drom in Enkhuizen for the coming years. The official signatures were placed under the contract for 3 years by Erik Jan Bartels of...

Sport and fun at the ISF golf tournament
19 April 2022: Incotec is sponsor at the ISF golf tournament at the Vallromanes Golf Club in Barcelona on 15 May.

See you at the ISF 2022
11 April 2022 : We are eager to show you what we have been doing. Visit our booth at the 2022 ISF for information on the latest sustainable seed enhancements or book an appointment to talk to a seed...

Xampla and Croda / Incotec to work on biodegradable seed coatings
02 February 2022 : A new partnership has been announced to develop next generation seed coatings that are not only microplastic-free but also fully biodegradable.

Incotec in action against litter
18 January 2022 : A team of Incotec colleagues are cleaning up litter in Enkhuizen in cooperation with a group of volunteers 'Schoon Enkhuizen' (Clean Enkhuizen)

Generous gesture at Christmas
14 December 2021 : "Giving is not just making a donation, it's making a difference". Incotec employees choose to donate their Christmas gratuity to charity.

Coming soon - new microplastic-free coatings for vegetable seeds
The vibrantly coloured film coatings are suitable for a wide range of vegetable seeds, compatible with commonly used plant protection products and perform well on parameters such as dust-off and...

Fluidus - the finishing touch in seed treatment
Fluidus F-038 is a very good alternative for existing finishing powders. Good dust control and a high colour intensity, but without titanium dioxide.

News : Incotec is first to market with microplastic-free pellet for lettuce seeds
First microplastic-free seed coating for lettuce in North America. The first of a new range of seed coatings that are ready for anticipated regulatory changes.

Newsletters: microplastics and the seed industry
Keeping you informed about updates in the regulation of microplastics and the development of microplastic-free solutions.

Opinion : Are microplastic-free solutions here to stay?
Marta Dobrowolska discusses the expected bans on the use of microplastics in seed coatings and the impact of this on the seed industry.

Opinion : Three ways to feed the world sustainably
How can our industry help towards achieving global food security in a sustainable way?
Would you like more information on any of these articles?

Microplastic-free seed coatings
Helping customers get ahead of the ban on miicroplastics in seed coatings, we are expanding our line of microplastic-free products for vegetables and field crops.
Read more